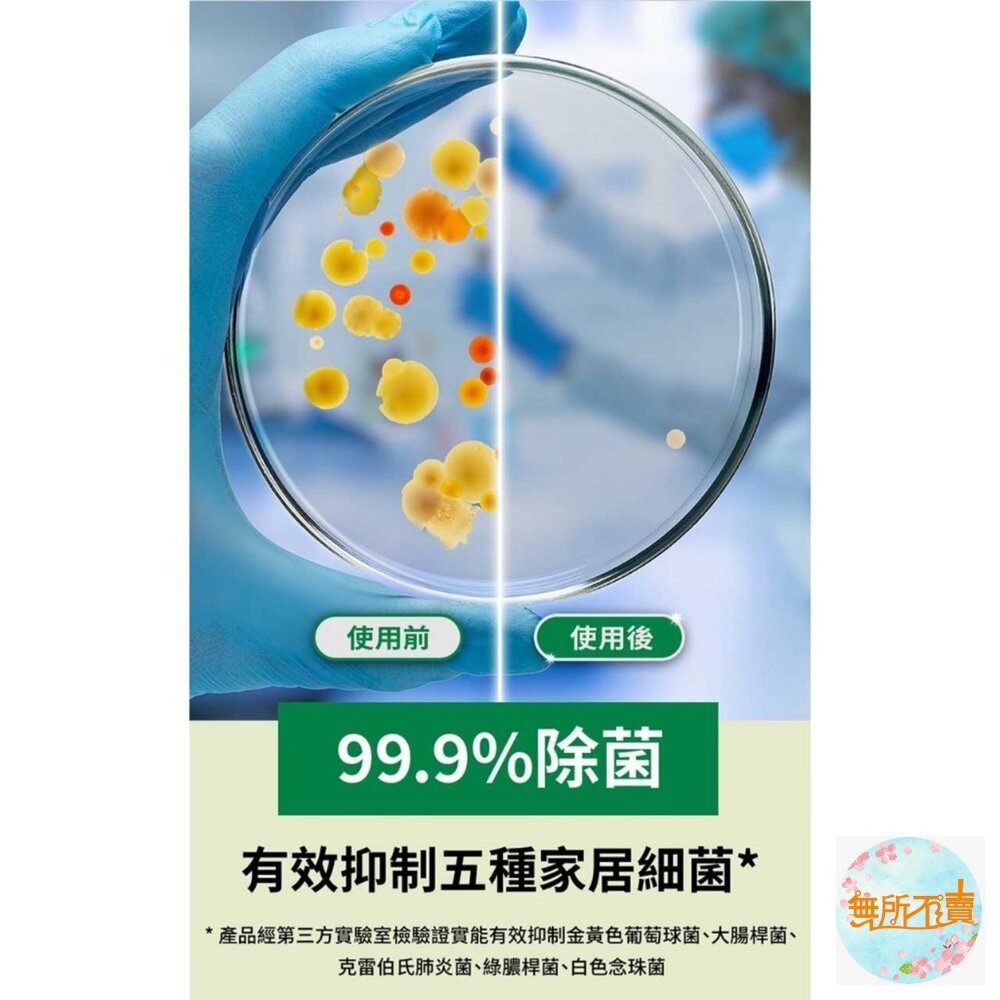

3M 百利餐具專用大黃菜瓜布 41YL-3M, 3片裝
$43
商品圖片

庫存表
| 尺寸 | |
|---|---|
| 3M 靜電除塵乾拖巾 30張入 | 現貨 93 件 |
| 3M 五合一除菌濕拖巾 12張入 | 現貨 60 件 |
商品描述
品名:3M 乾濕兩用 省力型拖把組
包裝、產品全新設計,使用體驗更升級。
---------------------
內容物:拖把、靜電乾拖巾x5片。
尺寸:
拖把高度:126cm。
拖把面板:25x11.5cm。
產地:中國。
---------------------
品名:3M 靜電除塵乾拖巾(無香味)
內容物:靜電除塵乾拖巾x30片。
成分:不織布+靜電處理。
尺寸:21 x 28 cm。
產地:中國。
---------------------
品名:3M 五合一除菌濕拖巾(清新橙香)
內容物:五合一除菌濕拖巾x12片。
成分:不織布、RO純水、季銨鹽、界面活性劑。
尺寸:21 x 28 cm。
產地:中國。
運送與付款
運送方式:7-11, 全家, 萊爾富, OK超商, 宅配
付款方式:線上刷卡, ATM轉帳, 超商取貨付款
供貨模式:現貨
配送溫層: 常溫